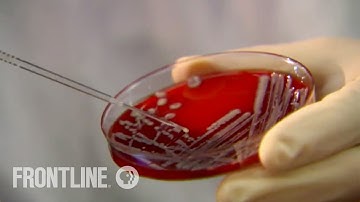
HUNTING THE NIGHTMARE BACTERIA | Drug resistant superbugs

⬇ DOWNLOAD NOW
Kalau muncul iklan pop-up, tutup lalu klik tombol kembali
Download lagu Deadly Superbug and What You Need to Know secara gratis hanya untuk keperluan promosi. Dukung artis favorit kamu dengan membeli musik original di iTunes atau platform resmi lainnya.
 The Rise of Deadly Superbugs: What You Need to Know
The Rise of Deadly Superbugs: What You Need to Know
 When Antibiotics Don't Work (full documentary) | FRONTLINE
When Antibiotics Don't Work (full documentary) | FRONTLINE
 Superbugs And Antibiotics: How To Prevent Superbug Bacteria | Better | NBC News
Superbugs And Antibiotics: How To Prevent Superbug Bacteria | Better | NBC News
 The Battle Against Superbugs: What You Need To Know | TIME
The Battle Against Superbugs: What You Need To Know | TIME
 Nightmare Bacteria Rising: The Deadly Superbug Threat Explained | WION Podcast
Nightmare Bacteria Rising: The Deadly Superbug Threat Explained | WION Podcast
 Battle Against Bacteria: A Race Against The 'Superbug' | Disease Hunters | Part 2/3
Battle Against Bacteria: A Race Against The 'Superbug' | Disease Hunters | Part 2/3
 The Concerning Antibiotic-Resistant Superbugs You Need to Know About
The Concerning Antibiotic-Resistant Superbugs You Need to Know About
HUNTING THE NIGHTMARE BACTERIA | Drug resistant superbugs
HUNTING THE NIGHTMARE BACTERIA | Drug resistant superbugs